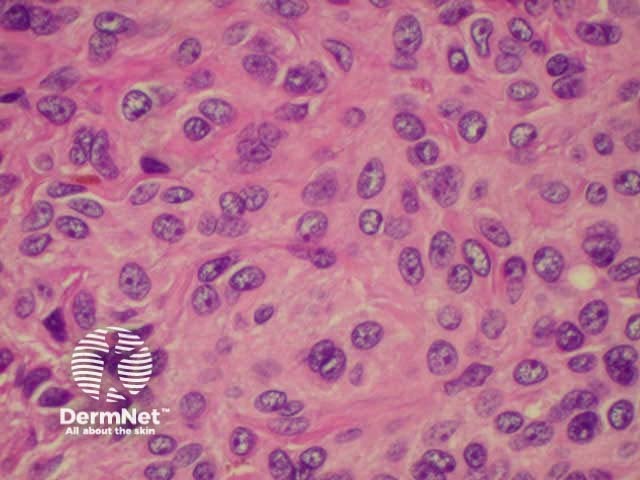
Superficial epithelioid naevus cells
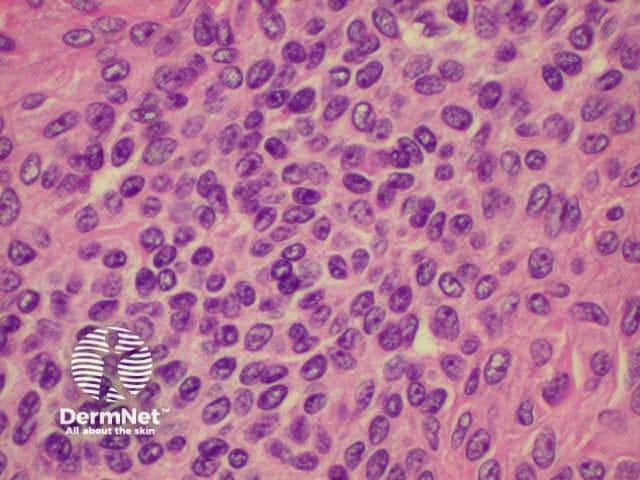
Deeper small dark naevus cells

Main menu
Common skin conditions
NEWS
Join DermNet PRO
Read more
Quick links
Created 2008.
In the embryo, melanocytes are derived from stem cells in the neural crest that normally migrate to the epidermis, where they are scattered along the basal layer. Melanocytes produce melanin within cytoplasmic packets called melanosomes. These contain greater amounts of melanin in darker skinned individuals. The melanin is distributed to keratinocytes via dendrites when stimulated by exposure to ultraviolet radiation and other factors.
Proliferation of melanocytes may result in congenital or acquired benign melanocytic naevi. These present as persisting macules, papules, plaques and nodules. Melanocytic lesions may be due to:
Most melanocytic lesions are pigmented, but dermal naevi often present as skin coloured or pink lesions. In general darker skin types have darker moles. Sun exposure leads to a greater number of lesions, but they are not confined to sun exposed sites.
Congenital melanocytic naevi are present at birth, or arise within the first two years of life. Moles that look like congenital naevi, but appear later in life, are sometimes called ‘congenital type’ naevi. Congenital naevi may be small (1-5cm), medium (1.5-20cm) or rarely, giant (bathing trunk variety). Congenital naevi may be macular but are frequently varied in pigment, thickened (‘cobblestoned’) and hairy, particularly post adolescence in males. Giant naevi have a significantly increased risk of melanoma in the lesion (5-10%) or within melanocytes in the central nervous system hence surveillance should be lifelong.
Café-au-lait macules are flat coffee-coloured patches. Solitary lesions are common. The presence of six or more is strongly suggestive of type 1 neurofibromatosis. Café-au-lait macules may also arise in other genetic syndromes, including Albright syndrome. A speckled lentiginous naevus (also called ‘naevus spilus’) is the association of a café-au-lait macule with darker lesions. There are two types.
Small congenital naevus Small congenital naevus Medium hairy congenital melanocytic naevus Giant congenital melanocytic naevus Café au lait macule (neurofibromatosis) Speckled lentiginous naevus (naevus spilus) 





Acquired melanocytic naevi, or moles, are sometimes called naevocellular naevi. Most people have about 20 to 50 moles.
A few naevi appear in infancy. These are thought to be due to spontaneous mutations in utero (tardive congenital naevi). They rarely regress.
Sun exposure promotes new naevi to appear during adolescence and adult life, but these tend to involute after the age of 50. Intermittent exposure to ultraviolet radiation may induce B-RAF or N-RAS mutations within the melanocytes. These naevi have a higher risk of acquiring further mutations and becoming melanoma.
Junctional naevus Compound naevus Dermal naevus Blue naevus Mongolian spot. Dermal melanocytosis Unna naevus 





Histology is shown below.
Histology of intradermal naevus Superficial epithelioid naevus cells Deeper small dark naevus cells

Halo naevi (also called ‘Sutton's naevi’) are common in teenagers and are most obvious in tanned skin. There are junctional, compound and dermal halo naevi. A white ring appears around one or more normal moles (Stage 1), which gradually fade (Stage II) and eventually disappear (Stage III). It may take several years for the white marks to disappear (Stage IV). Multiple halo naevi are associated with vitiligo, and rarely with metastatic melanoma. Histologically there is a dense lichenoid infiltrate.
Halos may also arise around atypical naevi and blue naevi; and they are also seen around non-melanocytic skin lesions such as seborrhoiec keraoses, basal cell carcinomas and inflammatory eruptions. An asymmetric irregular halo may develop around a primary melanoma.
Multiple halo naevi Early halo naevus Naevus slowly disappearing Halo around melanoma 



Spitz naevi are dome-shaped papules or nodules that most often arise on the face or limbs of children and adolescents. They enlarge over a few months, and are often red or deeply pigmented, resembling melanoma. In adults, they are often excised to rule this out.
The pathologist may also find it difficult to distinguish the biologically benign Spitz naevus from malignant melanoma. In the past, Spitz naevi were also called ‘juvenile melanoma’, but this term is no longer approved because it contributes to prognostic confusion. Histological descriptions usually refer to a symmetrical compound naevus in which maturing melanocytes are noted in the deeper dermis, and an epithelioid cell structure. Atypical Spitz naevus can be impossible to differentiate from melanoma, so is best removed with generous excision margins and followed up carefully.
Melanocytes in some Spitz naevi have been shown to have H-RAS type mutations. B-RAF and N-RAS mutations seen in acquired naevi and melanoma do not occur in Spitz naevi.
Types of Spitz naevi include:
Classic Spitz Classic Spitz Pigmented Spitz Atypical Spitz 



Reed naevus is sometimes classified separately from Spitz naevus but may co-exist with Spitz naevus. The Reed naevus also tends to be seen most often in children and present as dark brown to black papules on hands, feet or elsewhere. The pathology reveals spindle-shaped melanocytes in the dermis.
Reed naevus Reed naevus 3 macro Reed naevus Reed naevus 



Atypical naevi are ‘funny-looking’ moles. They may be more numerous, larger in size (over 4mm diameter), and varied in colour (usually shades of brown), shape, and contour (with an ill-defined border). Certain atypical naevi, classified as dysplastic naevi (also called Clark's naevi), may resemble melanoma and may also predispose to melanoma, especially in patients with a strong family history of atypical naevi and melanoma (dysplastic naevus syndrome). There is an autosomal dominant mode of inheritance.
No reliable clinical criteria exist to allow precise distinction between ‘normal’ naevi, those with degrees of atypia, and melanoma. Dysplastic naevi may occur on sun exposed and non-sun exposed sites. Melanoma may arise within a dysplastic naevus or de novo.
Clinical features of dysplastic naevi may include:
Histologically, diagnosis of dysplastic naevus requires the presence of two specific major criteria and two of four defined minor criteria. These relate to arrangement of the melanocytes in a lentiginous pattern, fibroplasia and dermal lympocytic infiltration.
Atypical naevus Atypical naevus Atypical naevus Atypical naevus 



Melanocytic naevi arising in mucosal skin, acral skin and flexural skin may show atypical features because of their location. However, malignancy is no more likely in these sites than in other common acquired naevi.
Melanocytic naevi can also arise within the nail matrix, resulting in a uniform linear band of pigment within the nail plate.
Acral naevus Nail naevus Nail naevus Nail naevus 





Freckles (lentigines) are evenly pigmented brown macules. The freckles arising on the nose and cheeks of young children following sun exposure are due to localised increase in melanin production from normal melanocytes. They fade during the winter months, reappearing in summer. More persistent freckles on the face and hands of adults are due to a proliferation of melanocytes along the basal layer.
Solar lentigines may appear similar to pigmented actinic keratoses (adherent scale and tenderness) or flat seborrhoeic keratoses (dry surface).
Most melanocytic lesions can be ignored, as they are harmless. Sun exposure increases the number and degree of atypicality of moles, a good reason for encouraging sun protection.
Moles may be removed for the following reasons:
Surgical removal may entail:
The coarse hair that sometimes grows in a mole can be removed by shaving. Plucking may cause inflammation resulting in a painful lump under the mole. The hair can only be removed permanently by electrolysis, laser epilation or excision of the whole mole.
Skin lesions that have been removed surgically should always be sent for pathology. If there is concern that a lesion could be a melanoma, it should be completely excised with 2-3 mm margin. If the lesion is too big for this to be practical or the scar will be unsightly, it is preferable to send the patient to a dermatologist for a specialist opinion. Incisional biopsy should be generous (punch biopsy is best avoided).
The number of lentigines increases with age and can be reduced by careful sun protection.
Providing there is no chance that an individual lesion is a melanoma, the following may be helpful to fade freckles:
Results are variable but sometimes very impressive with minimal risk of scarring.
Resurfacing lasers (carbon dioxide and Erbium:YAG) that vaporise the surface skin, and cryotherapy, should not be used to remove pigmented lesions by non-specialists. Although they may improve the appearance of lentigines, they may instead result in unsightly patchy hypopigmentation or scarring.
Examine a selection of patients. How do melanocytic naevi change with age and skin phototype?
Information for patients
See the DermNet bookstore